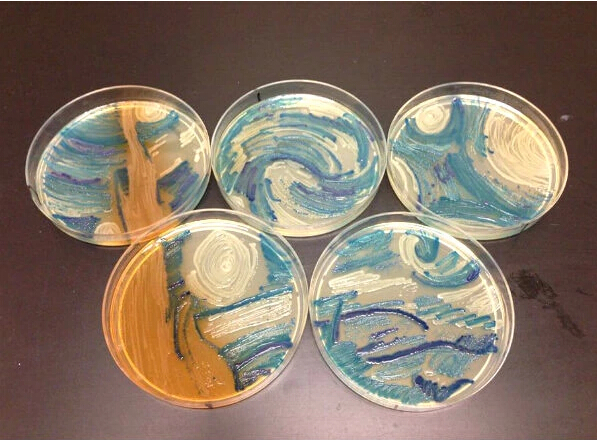
clip_image009.jpg
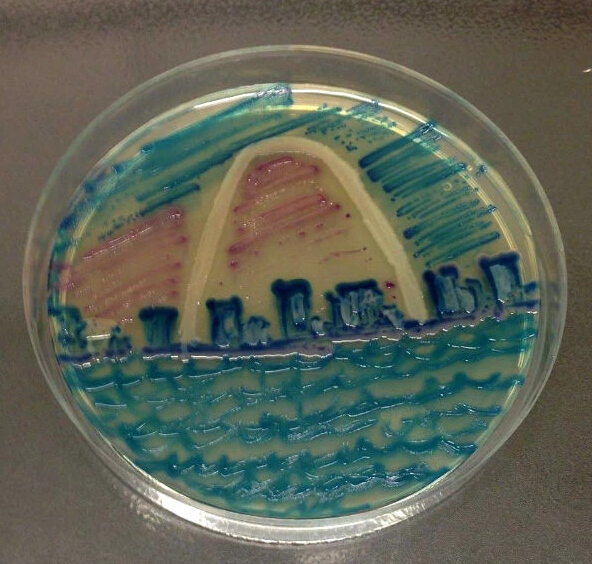
clip_image011.jpg
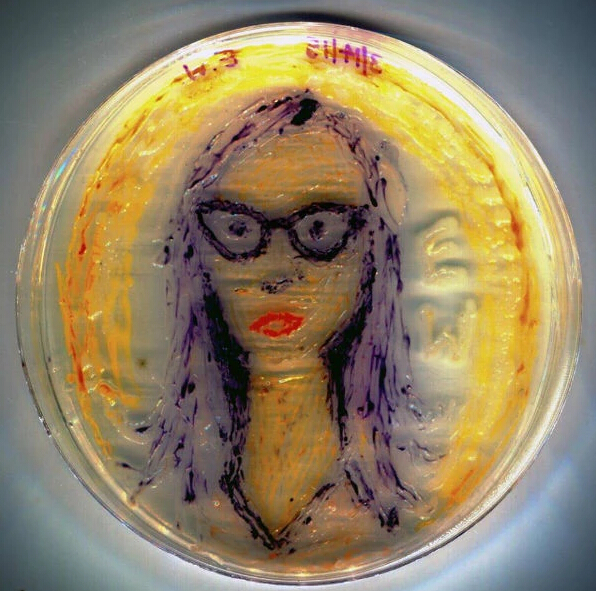
clip_image012.jpg

【轉(zhuǎn)載】微生物繪畫大賽-復(fù)制梵高《星空》
2016-03-16 13:33:303829次瀏覽
科普 轉(zhuǎn)載 自網(wǎng)絡(luò)
說起細菌:

你可能會聯(lián)想到……

但絕不會聯(lián)想到……

梵高的《星空》?
別鬧……
細菌和油畫怎能扯上關(guān)系?
科學(xué)家說:要扯得。


……
美國一群微生物科學(xué)家啟動了這項史無前例的藝術(shù)競賽……
以細菌和培養(yǎng)皿為畫筆和畫板。
經(jīng)過激烈的……化學(xué)反應(yīng),三甲誕生。
一起來品鑒……品鑒一下……
冠軍作品:《神經(jīng)元》(果然還是科學(xué)家啊……)

亞軍作品:《紐約生態(tài)地圖》

作者深情地說:紐約是座文化大熔爐……每個人都有自身獨特的微生物……(“New York City is a melting pot of cultures - both human and microbial - and every citizen has a personalized microbiome.”)
季軍作品:《豐收季節(jié)》

其他有力競爭者:
《微生星空》

這是用細菌畫了個細胞,三筆不離本行啊
據(jù)說這描繪的是美國城市圣路易斯
人像作品


